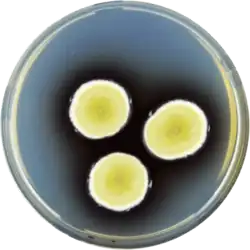

Aspergillus funiculosus
| Aspergillus funiculosus | |
|---|---|
| |
| Scientific classification | |
| Kingdom: | Fungi |
| Division: | Ascomycota |
| Class: | Eurotiomycetes |
| Order: | Eurotiales |
| Family: | Aspergillaceae |
| Genus: | Aspergillus |
| Species: | A. funiculosus
|
| Binomial name | |
| Aspergillus funiculosus G. Sm., 1956[1]
| |
Aspergillus funiculosus is an anamorph species of fungus in the genus Aspergillus.[2][1] Aspergillus funiculosus produces the funiculolides A-D and the antibiotic funicin.[3][4][5]
References
- ^ a b "Taxonomy browser (Aspergillus funiculosus)". www.ncbi.nlm.nih.gov.
- ^ "Aspergillus funiculosus Smith, anamorph | ATCC". www.atcc.org.
- ^ Nakamura MA, Fukuyama KE, Tsukihara T, Katsube Y, Hamasaki T (15 February 1983). "Structure of funicin, antimicrobial substance from Aspergillus funiculosus, C17H18O5". Acta Crystallographica Section C Crystal Structure Communications. 39 (2): 268–270. doi:10.1107/S0108270183004357.
- ^ Buckingham J (1987). Dictionary of Organic Compounds. Taylor & Francis. p. 343. ISBN 978-0-412-17050-8.
- ^ Yan D, Matsuda Y (April 2021). "Genome Mining-Driven Discovery of 5-Methylorsellinate-Derived Meroterpenoids from Aspergillus funiculosus". Organic Letters. 23 (8): 3211–3215. doi:10.1021/acs.orglett.1c00951. PMID 33821662. S2CID 233036269.
Further reading
- Schanz D (1978). Antibiotica aus aspergillus funiculosus untersuchungen zur isolerung (in German).